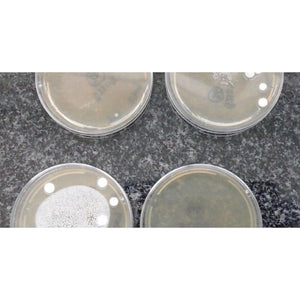

{"id":5977325928607,"title":"Sani UV-C Sterilisation Cabinet for Non-Liquid Disinfection","handle":"sani-uv-c-sterilisation-cabinet-for-non-liquid-disinfection","description":"\u003cp\u003e\u003cstrong\u003eProduct Description:\u003c\/strong\u003e\u003c\/p\u003e\n\u003cp\u003eThe Sani UV-C Sterilisation Cabinet offers advanced non-liquid disinfection without leaving any residue or requiring neutralisation after use. Designed for medical personnel, schools, and supply chain organisations, it efficiently inactivates germs, viruses, and bacteria present on shared devices and tools. Ideal for sanitising stores, small businesses, and personal care services, this cabinet ensures a high standard of cleanliness and hygiene. It's equipped with UV-C technology, including GUV and UV-C wavelengths, providing effective sterilisation and sanitation for various applications.\u003cbr\u003e\u003c\/p\u003e\n\u003cp\u003e\u003cstrong\u003eIndustry Application \u0026amp; Tags:\u003c\/strong\u003e\u003c\/p\u003e\n\u003cp\u003eMedical, Laboratory, Seed disinfection, Specified equipment, UV, GUV, UV-C, Ultraviolet, UV Sterile, Sanitise, Sterilisation, Lighting, Sanitation\u003c\/p\u003e\n\u003c!----\u003e","published_at":"2024-06-19T00:17:24+02:00","created_at":"2020-12-08T12:58:09+02:00","vendor":"SelectTechWesbite","type":"UV and Ozone","tags":["36 UV OZONE GENERATOR","Ozone","Ozone Sanitation Systems","UV"],"price":0,"price_min":0,"price_max":0,"available":true,"price_varies":false,"compare_at_price":null,"compare_at_price_min":0,"compare_at_price_max":0,"compare_at_price_varies":false,"variants":[{"id":37225844572319,"title":"Default Title","option1":"Default Title","option2":null,"option3":null,"sku":"","requires_shipping":true,"taxable":true,"featured_image":null,"available":true,"name":"Sani UV-C Sterilisation Cabinet for Non-Liquid Disinfection","public_title":null,"options":["Default Title"],"price":0,"weight":0,"compare_at_price":null,"inventory_management":"shopify","barcode":"","requires_selling_plan":false,"selling_plan_allocations":[],"quantity_rule":{"min":1,"max":null,"increment":1}}],"images":["\/\/selectech.co.za\/cdn\/shop\/files\/Sani_Super_Cabinet_1400x_52bf1e7d-2d58-4128-a21e-775a72bdbd60.jpg?v=1718749535","\/\/selectech.co.za\/cdn\/shop\/files\/SaniUV-Csterilizationcabinet-2.jpg?v=1718748327"],"featured_image":"\/\/selectech.co.za\/cdn\/shop\/files\/Sani_Super_Cabinet_1400x_52bf1e7d-2d58-4128-a21e-775a72bdbd60.jpg?v=1718749535","options":["Title"],"media":[{"alt":null,"id":33091778936991,"position":1,"preview_image":{"aspect_ratio":1.0,"height":1000,"width":1000,"src":"\/\/selectech.co.za\/cdn\/shop\/files\/Sani_Super_Cabinet_1400x_52bf1e7d-2d58-4128-a21e-775a72bdbd60.jpg?v=1718749535"},"aspect_ratio":1.0,"height":1000,"media_type":"image","src":"\/\/selectech.co.za\/cdn\/shop\/files\/Sani_Super_Cabinet_1400x_52bf1e7d-2d58-4128-a21e-775a72bdbd60.jpg?v=1718749535","width":1000},{"alt":null,"id":33090388623519,"position":2,"preview_image":{"aspect_ratio":1.0,"height":1000,"width":1000,"src":"\/\/selectech.co.za\/cdn\/shop\/files\/SaniUV-Csterilizationcabinet-2.jpg?v=1718748327"},"aspect_ratio":1.0,"height":1000,"media_type":"image","src":"\/\/selectech.co.za\/cdn\/shop\/files\/SaniUV-Csterilizationcabinet-2.jpg?v=1718748327","width":1000}],"requires_selling_plan":false,"selling_plan_groups":[],"content":"\u003cp\u003e\u003cstrong\u003eProduct Description:\u003c\/strong\u003e\u003c\/p\u003e\n\u003cp\u003eThe Sani UV-C Sterilisation Cabinet offers advanced non-liquid disinfection without leaving any residue or requiring neutralisation after use. Designed for medical personnel, schools, and supply chain organisations, it efficiently inactivates germs, viruses, and bacteria present on shared devices and tools. Ideal for sanitising stores, small businesses, and personal care services, this cabinet ensures a high standard of cleanliness and hygiene. It's equipped with UV-C technology, including GUV and UV-C wavelengths, providing effective sterilisation and sanitation for various applications.\u003cbr\u003e\u003c\/p\u003e\n\u003cp\u003e\u003cstrong\u003eIndustry Application \u0026amp; Tags:\u003c\/strong\u003e\u003c\/p\u003e\n\u003cp\u003eMedical, Laboratory, Seed disinfection, Specified equipment, UV, GUV, UV-C, Ultraviolet, UV Sterile, Sanitise, Sterilisation, Lighting, Sanitation\u003c\/p\u003e\n\u003c!----\u003e"}